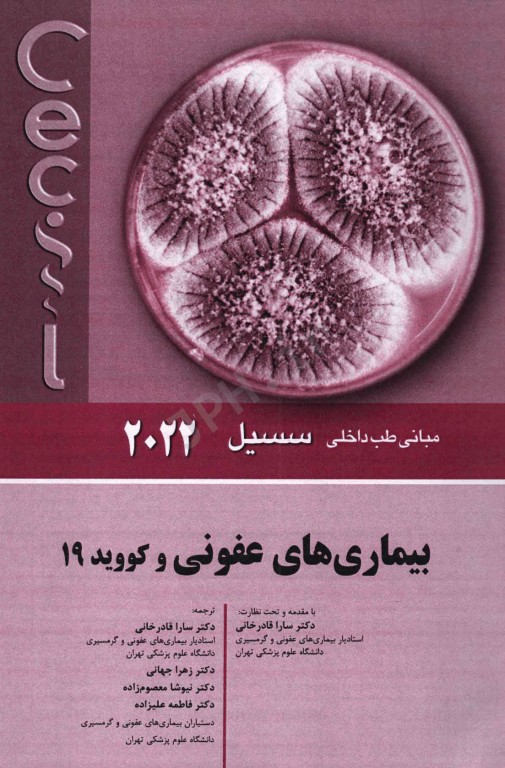
مبانی طب داخلی سسیل 2022 بیماری‌های عفونی و کووید 19

کتاب مبانی طب داخلی سسیل 2022 بیماریهای عفونی و کووید 19 تالیف ادوارد جی وینگ و فرد جی شیفمن ترجمه دکتر سارا قادرخانی، دکتر زهرا جهانی، دکتر نیوشا معصوم زاده، دکتر فاطمه علیزاده با مقدمه و نظارت دکتر سارا قادرخانی توسط انتشارات اندیشه رفیع به چاپ رسیده است. با توجه به پاندمیها و اپیدمیهایی ک با عوامل مختلفی در حال رخ دادن است، متوجه ارزش والای دانش عفونی در جوامع میشویم.
فهرستی وارد نشده است
میتوانید از مشاهده داخل کتاب استفاده کنید